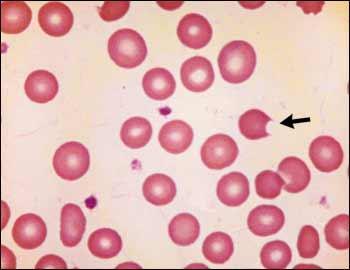
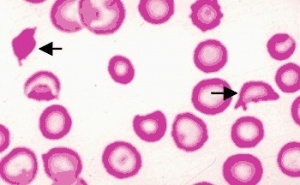

Bone marrow sampling is used for what?
Evaluate anemia Diagnose leukemia and lymphoma Document bone marrow infiltratative diseases
Carboxyhemoglobin is used for what?
Used to detect carbon monoxide poisoning
Blood coagulation process

Dacrocytosis/Tear Drop Cells

Effects of protein C/S deficiency:
pregnancy loss; strokes; DVT
Know what the WBCs (
leukocytes) look like:

Life cycle of a red blood cell

What are codocytes/Target cells ?
Have a central density instead of a central clearing
Associated with thalasemias, liver disease and asplenia

. What are Degmacytes/Bite cells ?
Red blood cells that look like cookies with a bite taken out of them
* This occurs when immune cells recognize and
remove abnormal hemoglobin *G6P deficiet
What are Depranocytes AKA sickle cells ?
Genetic Hgb abnormality
Cells take this shape on due to hypozia and acidosis

What are Echinocytes/Acanthocytes/Burr Cells ?
Have a “spiky” look
Causes: liver disease, uremia, genetics

What are schistocytes/helmet cells?
They are red blood cells that have fragements sheared off
Due to fibrin strands
Mechanical heart valves can smash cells Hemolytic anemia
DIC
Whatis basophilic
stippling?
It is the presence of punctuate blue nucleic acid remnants in RBCs;
it is a characteristic of lead toxicity

What is the CBC shorthand?

What is spherocytosis ?
Hereditary
Cells fragile –> recognized by spleen and destroyed



